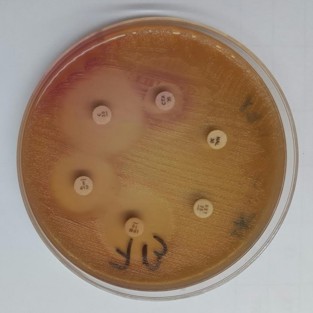

Las bacterias en su estado natural, tal como se encuentran en el ambiente, presentan algún grado de resistencia frente a determinados medicamentos antimicrobianos. Ante el constante enfrentamiento a diferentes antibióticos utilizados tanto en humanos como en animales, estos microorganismos se vuelven cada vez más resistentes.
Técnicamente a esto se lo conoce como Resistencia Natural Antimicrobiana y es un área de investigación en el que la Organización Panamericana para la Salud puso especial interés.
Las consecuencias que tiene el tema para la salud pública, generó a través del Servicio de Antimicrobianos del Instituto Nacional de Enfermedades Infecciosas ANLIS “Dr Carlos G. Malbrán” un programa de investigación del que participa el Instituto de Medicina Regional de la UNNE.
La especial atención que se le viene dando al tema, tiene como uno de sus motivos el incremento exponencial de los costos de la atención sanitaria. Cuando las infecciones se vuelven resistentes a los medicamentos de primera línea es preciso utilizar terapias más costosas. La mayor duración de la enfermedad y su tratamiento, frecuentemente en hospitales, eleva los costos de atención sanitaria y la carga económica para las familias y el estado.
Los organismos resistentes (bacterias, hongos, virus y algunos parásitos) pueden soportar ataques de medicamentos antimicrobianos tales como antibióticos, fungicidas, antivirales y antipalúdicos, de tal forma que los tratamientos convencionales se vuelven ineficaces y las infecciones persisten, lo que incrementa el riesgo de propagación.
Convocatoria. La convocatoria realizada hace pocos días atrás por el Ministerio de Salud de la Provincia del Chaco al Instituto de Medicina Regional, tiene una función concreta que bien lo explica su director el bioquímico Luis Antonio Merino.
“El Instituto será el encargado de determinar, mediante estudios genéticos, cuáles son los mecanismos involucrados en la resistencia antimicrobiana de las bacterias obtenidas de las diferentes poblaciones analizadas, con el objeto de aclarar algunos aspectos relacionados con la prevención y el control de su diseminación”.
Para el doctor Merino, quien además es el jefe del área de Bacteorología del Instituto, encarar esta línea de trabajo es importante para conocer “la situación de las bacterias provenientes de personas sanas con poco o nulo contacto con antimicrobianos (poblaciones aborígenes aisladas, por ejemplo) y compararlas con aquellas provenientes de personas que son tratadas frecuentemente con antibióticos. De esta forma se sabrá en qué medida el uso irracional de esos medicamentos influyen en la aparición de bacterias resistentes”.
El proyecto involucrará además a los laboratorios más importantes de la provincia del Chaco y a la Red de Laboratorios del subsector privado de la Salud de esa provincia. No se descarta que en una etapa posterior, el estudio se haga extensivo a la provincia de Corrientes.
Tras agradecer la convocatoria, el doctor Merino expresó “desde la Universidad complementamos esfuerzos con Salud Pública, mientras ellos se dedican a la asistencia directa a los pacientes, nosotros aportamos técnicas y protocolos de investigación. De esta manera conseguimos mayores resultados, potenciando los recursos”, agregó.
Fuente: http://www.corrienteshoy.com

No hay comentarios aún.